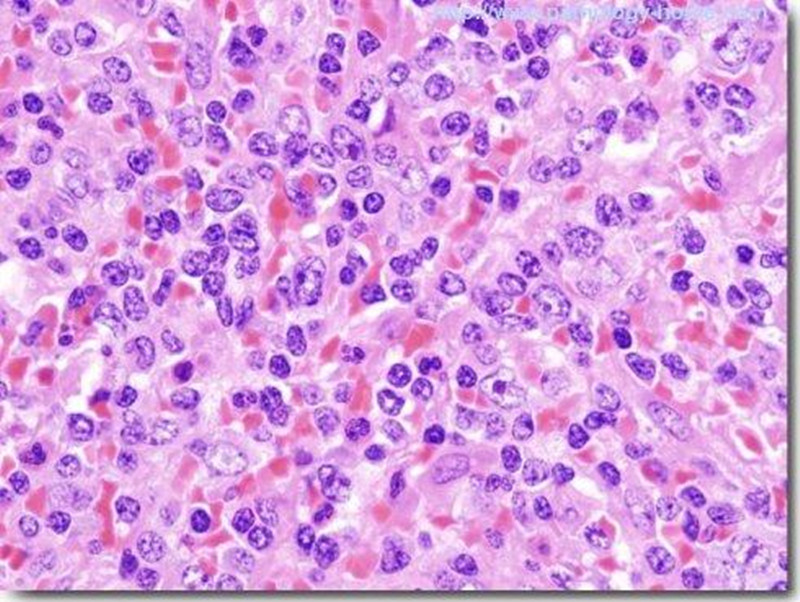

专病门诊|我院肿瘤内科开设淋巴肿瘤专病门诊
近年来以恶性淋巴瘤为代表的淋巴肿瘤发病率上升较快,居我国恶性肿瘤发病率第7位。淋巴瘤的预后与肿瘤的病理组织类型和临床分期以及是否采取合适的治疗手段密切相关,其中早期霍奇金淋巴瘤采用化疗、放疗等综合治疗,目前治愈率高达90%以上。非霍奇金淋巴瘤具有高度异质性,由属于不同病理类型和恶性程度的疾病组成,不同类型的临床表现及治疗方法差异较大,预后也完全不同。随着综合治疗经验的积累以及新药、新的联合方案的发展,使得恶性淋巴瘤的近期疗效和远期生存都逐渐提高,已在相当程度上成为可治愈之症。
由于恶性淋巴瘤治愈率较高,因此首次治疗是否规范直接影响患者预后。淋巴瘤病理分型复杂,诊断及治疗理念与其它实体肿瘤存在很大差异,且淋巴瘤会在多器官发病,故患者分散就诊于各个科室,不利于规范化诊断及治疗。

中枢淋巴瘤核磁图片
为了规范淋巴瘤诊断、治疗及随访,肿瘤内科开设了淋巴肿瘤专病门诊,由具有丰富临床经验的专业医师定期出诊,为广大患者提供优质的医疗服务。
淋巴瘤病理图片
淋巴瘤学科带头人为肿瘤内科副主任贾友超,团队目前拥有高级职称2人,中级职称3人,博士1人,在读博士2人,团队成员曾于中山大学肿瘤医院、北京大学肿瘤医院淋巴瘤科进修学习,目前承接淋巴瘤相关多中心临床试验5项。与京津、广州、上海等高水平淋巴瘤中心建立了良好的临床和科研协作关系,目前为华北淋巴瘤协作组成员单位,连续举办第一届、第二届雄安淋巴瘤论坛,并计划牵头发起“医带一路”多省区淋巴瘤巡讲。在医院层面,牵头成立淋巴瘤多学科诊疗团队,与病理科、CT-MRI诊断科、核医学科、头颈外科等科室协作,对复杂、疑难淋巴瘤诊疗给出合理建议。
专家出诊时间:
贾友超 周二上午 副主任医师
韩强 周五上午 主任医师
专家出诊地点:
河北大学附属医院北院门诊三层肿瘤内科1诊室
专家出诊时间:
贾友超 周五上午 副主任医师
专家出诊地点:
河北大学附属医院本部1号楼A座三层肿瘤科门诊1诊室
文/图:肿瘤内科
编辑:董媛媛 闫紫薇